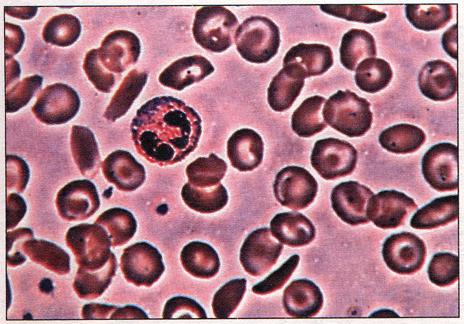

|
Черил Генри никогда не считала себя энергичной, но после потери "этих последних четырех килограммов" она почувствовала себя настолько обессиленной, что ей хотелось забраться в постель уже в полдень. "Хорошо, что на службе я большую часть времени могу сидеть, - говорит 33-летняя секретарша и мать двоих детей, - потому что я не смогла бы выдержать работу, требующую больших физических усилий".
Получалось так, что, придя домой после работы, Черил сразу должна была прилечь на диван. "Пока я отдыхаю, мой муж занимается ужином, - говорит она, восхищаясь его терпением, - а после еды я
надеваю пижаму и ложусь в постель. Сколько бы я ни спала, к концу дня я чувствую себя как выжатый лимон. Я забыла, что такое совместные прогулки. Я не могу пройти и километра, чтобы не присесть отдохнуть. Я не живу". Черил говорит, что ей часто не хватает воздуха и у нее немного кружится голова: "Однажды я упала в обморок в церкви - прямо сползла со скамьи. Когда я пришла в себя, я услышала звуки органа и увидела много людей, окруживших меня. Я подумала, что умерла". Всего сказанного было достаточно, чтобы отправить ее к врачу. Простой анализ крови обнаружил причину плохого самочувствия Черил: у нее была железо-дефицитная анемия, болезнь "усталой крови", которая очень распространена у женщин.
Слово "анемия" переводится как "без крови". Звучит несколько преувеличенно, но если спросить Мерил, то окажется, что она так не думает. Кроме усталости и головокружений, у нее есть симптомы, свидетельствующие о тяжелой анемии, - у нее высокая частота пульса, низкое давление, головокружения часто бывают сильными, и наблюдается сильная слабость.
От чего это происходит? Энергетические возможности организма снижаются, когда он не получает достаточного количества железа, вещества, необходимого для образования гемоглобина в эритроцитах. Гемоглобин переносит кислород. Если железа не хватает, уровень гемоглобина падает и ткани и органы не получают достаточно кислорода, чтобы дать вам силы.
У женщин это бывает часто. Женщины теряют железо во время менструаций, особенно те, у которых менструации обильные. Сверх того, женщины склонны следить за своим весом, что увеличивает риск снижения запасов железа в организме. Большему риску подвержены также беременные женщины. Им нужно больше железа, потому что они делятся им с растущим ребенком. Специалисты подсчитали, чтожелезодефицитной анемией страдают 15 процентов менструирующих женщин и 30 процентов беременных.
Мерил рассказала, что у нее всегда были обильные менструации, которые стали еще обильнее после рождения двух детей. " Вначале я думала, что я очень устаю из-за детей и работы, хотя я работаю неполный рабочий день, - вспоминает она. - Конечно, это играет какую-то роль. Но вскоре я поняла, что я не просто устаю, со мной что-то не в порядке, и я должна выяснить - что".
"Железодефицитная анемия сама по себе не является болезнью, это симптом того, что в организме не все в порядке, - объясняет Сьюзен Мак-Клур, доктор медицины, доктор философии, профессор отделения гематологии и онкологии филиала медицинского факультета Техасского университета в Галвестоне. - Важно докопаться до причины. У большинства женщин такая анемия развивается в результате слишком большой потери крови во время менструаций и недостаточного содержания железа в рационе для восполнения его потери. Но, если у вас уже нет менструаций, ваш врач должен провести небольшое исследование".
Сильную потерю железа может вызывать целый ряд заболеваний, начиная от кровоточащих язв или геморроидальных узлов до более серьезных случаев, таких, как рак желудочно-кишечного тракта, хотя он встречается реже. Железодефицитная анемия не всегда проявляется тремя настораживающими симптомами, как это было у Мерил. Вы можете даже не подозревать о ее наличии, пока очередной анализ крови не обнаружит ее, рассказывает Сьюзен Мак-Клур. На самом деле у вас может быть пониженный уровень железа без выраженной анемии.
"Анемия может развиваться очень медленно, - говорит Мак-Клур. - Каждый месяц вы теряете немного крови, раз или два вы проходите через беременность, и запасы железа в вашем организме постепенно уменьшаются. Или вы все разгружаетесь, разгружаетесь, разгружаетесь, постоянно отказываясь от некоторых видов пищи, например мяса, которые совершенно необходимы.
Если вы ведете не очень активный образ жизни и если у вас здоровые сердце и легкие, вы не почувствуете потерю гемоглобина, пока содержание железа не станет совсем низким, - замечает она. - Просто удивительно, насколько организм способен компенсировать недостаток железа.
С другой стороны, если вы привыкли вести образ жизни, требующий больших физических усилий, например, вы регулярно занимаетесь бегом или плаванием, вы можете заметить упадок сил гораздо быстрее, - указывает Сьюзен Мак-Клур. - Или если анемия начинается внезапно - в результате быстрой потери крови, например при кровоточащей язве, или после очень обильных менструаций, - ее симптомы будут более выраженными".
Курение уменьшает содержание железаОбычный анализ крови позволяет определить наличие анемии - если только вы не курите. Если вы курите, у вас может быть анемия, даже если уровни содержания гемоглобина, который переносит кислород с потоком крови, оказываются в норме.
Вот что происходит. Моноокись углерода, содержащаяся в сигаретах, соединяясь с гемоглобином, образует вещество под названием карбоксиге-моглобин. Эта форма гемоглобина не обладает способностью переносить кислород. Чтобы компенсировать ухудшение снабжения тканей кислородом, у курильщиков повышается уровень гемоглобина в крови в сравнении с некурящими. Более того, чем больше сигарет вы выкуриваете, тем больше гемоглобина покажут результаты анализов, затрудняя распознавание возможной анемии.
Исследователи считают, что для выявления анемии у курильщиков нижние значения уровня гемоглобина, принимаемого за норму, нужно поднимать в зависимости от числа выкуриваемых за день сигарет. По этой причине, если вы курите, обязательно сообщите об этом вашему врачу.
"Из-за особенностей женского организма и в ряде случаев варварского отношения к собственному здоровью большинство женщин не получают из пищи хоть сколько-нибудь приближающегося к норме количества железа, - пишет Аннетт Натоу, доктор философии, специалист в области диетотерапии. - Если женщина, например, придерживается диеты, содержащей 1000 калорий в день, она, по всей вероятности, получает только 6 мг железа - ничтожно мало в сравнении с рекомендованными 15 миллиграммами. Даже если женщина потребляет 2000 калорий в день, что обычно гораздо больше того, что позволяет себе заботящаяся о своей фигуре женщина, она получает в среднем только около 12 миллиграмм железа". Добавьте к этому, что, если употреблять бедные железом продукты питания, такие, как творог, йогурт, салат, фруктовые соки, которые составляют значительную часть дневного рациона, вероятность железо дефицитной анемии еще более возрастает.
Специалисты говорят, что даже небольшое малокровие представляет собой симптом назревающей железодефицитной анемии, так как кровяные клетки не сразу реагируют на потерю организмом железа. Когда это случится, ваш врач посоветует вам пройти шестимесячный курс лечения препаратами железа. Вам потребуется также периодически проверять уровень гемоглобина в крови. Если усиленный прием препаратов железа не приведет к повышению гемоглобина, ваш врач проверит, нет ли других причин заболевания.
"Так как вы усваиваете только треть железа, содержащегося в препаратах, - говорит Сьюзен Мак-Клур, - вам потребуется принимать их длительное время, несмотря на то что обычно через месяц - два самочувствие заметно улучшается. Пациентки часто говорят мне, что они и не подозревали, как им было плохо, пока не начинали вновь обретать утраченные силы".
Конечно, в целом, пища, богатая железом, может помочь предотвратить возникновение анемии. Но употребление продуктов, содержащих много железа, не однозначно ведет к получению организмом достаточного его количества. Нужно учитывать еще и качество железа. Одни соединения железа поглощаются лучше (гем-железо), другие хуже. Кроме того, по-разному усваиваются продукты и компоненты пищи в разных сочетаниях.
Вот перечень продуктов, который поможет вам сбалансировать количество потребляемого железа. Ешьте постное мясо. Мясо - основной источник железа. Фактически гем-железо, усваиваемое лучше всего, найдено только в продуктах животного происхождения. Порция филея весом в 170 г даст вам, к примеру, 6 миллиграмм железа. Ешьте овощи и блюда из круп вместе с постным мясом. Многие зерновые и овощи являются хорошими источниками железа, но не гем-железа. Хотя организм усваивает только небольшой процент этой формы железа, употребление таких продуктов одновременно с мясом может способствовать лучшему его усвоению. Ешьте богатые железом бобовые. Сухие фасоль и горох - хорошие источники железа, включайте их в рацион. Если есть их с нежирным мясом, это также способствует лучшему усвоению содержащегося в них железа.
Учитывайте эффект кальция. Большое количество кальция и фосфора, содержащихся в молоке и сыре, может несколько препятствовать поглощению железа. Если вы употребляете и препараты железа, и препараты кальция, принимайте их в разное время.
Сочетайте пищу, богатую железом, с пищей с высоким содержанием витамина С. Витамин С улучшает усвоение железа, содержащегося в овощах, крупах, фруктах и орехах. Если вместе с богатой железом едой вы будете выпивать стакан апельсинового сока, количество усвоенного железа может более чем удвоиться. Не пейте чай или кофе сразу после еды. И не вымывайте препараты железа большим количеством кофе. Танин в этих напитках связывает железо, не давая ему поглощаться.
По возможности, готовьте пищу в чугунной посуде. В одном из опытов соус для спагетти, приготовленный медленным кипячением в течение 20 минут в чугунной кастрюле, содержал в 9 раз больше железа в сравнении с исходным продуктом. Железо, переходящее в пищу из материала посуды, не является легкоусвояемым, но оно обогащает ваш рацион. Ешьте обогащенные железом продукты. Каши на завтрак из обогащенных железом круп и другие продукты с добавками железа помогут вам набрать необходимое его количество. Но не полагайтесь исключительно на них, так как железо из них не всегда усваивается в достаточном количестве.
Нарушение функций молекул гемоглобина в крови вызывает анемию. Эти клетки крови, увеличенные в 900раз, взяты у человека, имеющего серповидно-клеточную аномалию эритроцитов.

Мертвенно-бледная рука пациента, страдающего железодефицитной анемией (слева) и нормальная рука здоровой женщины.

Для релаксации рекомендуется массаж тела с эфирным, маслом пупавки благородной и лимона.

Следите, чтобы ваше питание было полноценным и включало продукты, богатые железом, как те, что изображены здесь. Это очень важно при анемии.

Травники рекомендуют щавель курчавый, яснотку белую и тысячелистник, но травы нужно принимать под наблюдением специалиста.
| Главная страница |
|